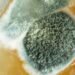
The Hidden Costs of DIY Mold Testing: What You're Not Considering

Insomnia is a common sleep disorder that affects millions of people worldwide. While there are many known causes of insomnia, including stress, anxiety, and certain medications, there is growing evidence that mold exposure may also be a contributing factor. Mold is a type of fungus that can grow in damp, humid environments, such as bathrooms, basements, and kitchens. When mold spores are inhaled, they can trigger a range of health problems, including respiratory issues, allergies, and even insomnia.

Understanding the link between mold and insomnia is important for those who suffer from this sleep disorder. While not all cases of insomnia are caused by mold exposure, it is essential to identify and address any potential environmental factors that may be contributing to sleep disturbances. This article will explore the relationship between mold and insomnia, how to identify mold in your environment, and steps you can take to prevent and control mold growth in your home.
Key Takeaways
- Mold exposure can cause a range of health problems, including insomnia.
- Identifying and addressing environmental factors, such as mold, is essential for those who suffer from insomnia.
- Preventing and controlling mold growth in your home can help reduce the risk of mold-related health issues.
Understanding Mold and Its Impact on Health

Mold is a type of fungus that grows in damp and humid environments. It can be found both indoors and outdoors and can cause a variety of health problems. Mold spores can be inhaled and cause respiratory issues, allergic reactions, and even mycotoxin poisoning in some cases.
Types of Mold and Associated Health Risks
There are many types of mold, but some are more harmful than others. Black mold, for example, is known to be particularly toxic and can cause serious health problems. Other types of mold, such as Aspergillus and Penicillium, can cause allergic reactions and respiratory issues in some people.
Mold can grow in many different places, including walls, ceilings, carpets, and furniture. It thrives in damp and humid environments, so it is important to keep your home dry and well-ventilated to prevent mold growth.
Recognizing Symptoms of Mold Exposure
Symptoms of mold exposure can vary depending on the individual and the severity of the exposure. Some people may experience mild symptoms such as sneezing, coughing, and watery eyes. Others may experience more severe symptoms such as difficulty breathing, chest tightness, and fatigue.
In some cases, exposure to mold can also lead to insomnia and other sleep-related problems. Studies have shown that mold exposure can disrupt our circadian rhythms and suppress the production of melatonin, a hormone that regulates sleep-wake cycles. This can lead to sleep disturbances and other health issues.
It is important to recognize the symptoms of mold exposure and take steps to prevent mold growth in your home. If you suspect that you have mold in your home, it is best to contact a professional mold remediation company to safely remove the mold and prevent future growth.
The Link Between Mold and Insomnia
Insomnia is a common sleep disorder that affects many people. It is characterized by difficulty falling or staying asleep, resulting in fatigue, excessive daytime sleepiness, and other health problems. While there are various causes of insomnia, research suggests that mold exposure may be a contributing factor.
How Mold Can Cause Sleep Disturbances
Mold is a type of fungus that grows in damp and humid environments. When mold spores are inhaled, they can irritate the respiratory system, causing inflammation and swelling. This can lead to breathing difficulties, which can make it difficult to fall asleep or stay asleep. In addition, mold exposure can trigger allergic reactions, which can cause sneezing, coughing, and other symptoms that interfere with sleep.
Mold Exposure and Sleep-Related Health Conditions
Studies have shown that mold exposure can also lead to sleep-related health conditions, such as obstructive sleep apnea. This is a condition in which the airway becomes blocked during sleep, causing breathing difficulties and snoring. Mold exposure can also disrupt the body’s circadian rhythms and suppress the production of melatonin, a hormone that regulates sleep-wake cycles. This can lead to sleep disturbances and other health issues.
In conclusion, mold exposure can cause or aggravate sleep disturbances, including insomnia. If you suspect that mold may be present in your home or workplace, it is important to take steps to address the issue. This may include identifying and removing sources of moisture, improving ventilation, and using air purifiers or dehumidifiers. By taking these steps, you can help improve your sleep quality and overall health.
Identifying Mold in Your Environment

Mold growth in homes can cause various health problems, including insomnia. Therefore, it is essential to identify mold in your environment and take necessary measures to prevent it. This section discusses common signs of mold growth in homes and mold detection and testing methods.
Common Signs of Mold Growth in Homes
The following are some common signs of mold growth in homes:
- Visible Mold: Mold growth can be visible on walls, ceilings, floors, and other surfaces. It can appear as black, white, green, or brown patches.
- Mold Odor: Mold growth produces a musty odor that can be easily noticeable.
- Humidity: High humidity levels can lead to mold growth. Humidity levels above 60% can promote mold growth.
- Condensation: Condensation on windows, walls, and pipes can be a sign of high humidity levels and can lead to mold growth.
- Water Damage: Water damage, such as leaks, floods, or water stains, can lead to mold growth.
Mold Detection and Testing Methods
The following are some mold detection and testing methods:
- Visual Inspection: A visual inspection can help identify visible mold growth and water damage.
- Moisture Meters: Moisture meters can determine the moisture content of building materials, which can help identify areas with high humidity levels that are prone to mold growth.
- Air Sampling: Air sampling can be used to determine the concentration of mold spores in the air. However, it is not always necessary and can be expensive.
- Surface Sampling: Surface sampling can be used to identify the type of mold present on surfaces. However, it does not provide information on the concentration of mold spores in the air.
In conclusion, identifying mold growth in your environment is crucial in preventing mold-related health problems, including insomnia. Common signs of mold growth include visible mold, mold odor, high humidity levels, condensation, and water damage. Mold detection and testing methods include visual inspection, moisture meters, air sampling, and surface sampling.
Health Effects of Mold in Different Populations

Mold exposure can affect different populations in different ways. The following subsections examine the impact of mold on vulnerable groups and those with chronic conditions.
Mold’s Impact on Vulnerable Groups
Children, the elderly, and those with weakened immune systems are more vulnerable to the health effects of mold exposure. Children who are exposed to mold may experience respiratory symptoms such as wheezing, coughing, and shortness of breath. Elderly individuals may experience similar symptoms, as well as an increased risk of infections. Those with weakened immune systems, such as individuals with HIV, may be at increased risk of fungal infections, which can be life-threatening.
Chronic Conditions and Mold Sensitivity
Individuals with chronic conditions such as asthma, allergic rhinitis, and autoimmune diseases may be more sensitive to mold exposure. Mold can trigger asthma symptoms such as wheezing, coughing, and shortness of breath. Those with allergic rhinitis may experience symptoms such as sneezing, runny nose, and itchy eyes. Individuals with autoimmune diseases may experience an exacerbation of their symptoms when exposed to mold.
Chronic fatigue syndrome (CFS) is another condition that may be aggravated by mold exposure. While the exact cause of CFS is unknown, some researchers believe that mold exposure may be a contributing factor. However, more research is needed to confirm this link.
In conclusion, mold exposure can have a significant impact on vulnerable populations and those with chronic conditions. It is important to take steps to prevent mold growth in indoor environments and to address any mold issues promptly to minimize the risk of health effects.
Preventing and Controlling Mold in Your Home
Mold is a common problem that can cause a range of health issues, including insomnia. Preventing and controlling mold growth in your home is essential to maintaining a healthy environment and getting a good night’s sleep. Here are some strategies to reduce indoor humidity and prevent mold growth.
Strategies to Reduce Indoor Humidity
One of the most effective ways to prevent mold growth is to keep indoor humidity levels low. The Environmental Protection Agency recommends keeping indoor humidity levels between 30% and 60%. Here are some strategies to reduce indoor humidity:
- Use a dehumidifier: A dehumidifier can help remove excess moisture from the air and reduce indoor humidity levels. Make sure to choose a dehumidifier that is appropriately sized for the room.
- Use a humidifier: In dry climates, a humidifier can help add moisture to the air and prevent dryness that can lead to mold growth.
- Increase ventilation: Proper ventilation can help reduce indoor humidity levels. Open windows and doors when possible, and use exhaust fans in bathrooms and kitchens.
- Use air conditioning: Air conditioning can help reduce indoor humidity levels by removing moisture from the air. Make sure to properly maintain your air conditioning system to prevent mold growth.
Cleaning and Maintenance to Prevent Mold
Regular cleaning and maintenance can help prevent mold growth in your home. Here are some tips:
- Fix leaks promptly: Leaks can lead to excess moisture and mold growth. Fix leaks promptly and thoroughly dry any affected areas.
- Clean and dry wet areas: Clean and dry any wet areas, such as bathrooms and kitchens, as soon as possible. Use a fan or dehumidifier to help dry the area.
- Use mold-resistant products: Use mold-resistant products, such as paint and drywall, in areas that are prone to moisture, such as bathrooms and basements.
- Regularly clean and maintain your home: Regularly clean and maintain your home to prevent mold growth. This includes dusting, vacuuming, and cleaning surfaces with a mold-killing solution.
By following these strategies, you can help prevent and control mold growth in your home and get a better night’s sleep.
Mold Remediation and Professional Help
When dealing with mold, it is important to take action as soon as possible to prevent it from spreading. In some cases, it may be necessary to seek professional mold remediation to ensure that the mold is properly removed and the affected area is thoroughly cleaned.
When to Seek Professional Mold Remediation
It is recommended to seek professional mold remediation if:
- The mold covers a large area (greater than 10 square feet)
- The mold is caused by contaminated water (such as from a sewage backup)
- The mold is affecting the HVAC system or other hard-to-reach areas
- The mold is causing health problems for individuals in the home
Professional mold remediation companies have the necessary equipment and expertise to safely remove mold and prevent it from spreading to other areas. They can also identify and address the underlying cause of the mold, such as water leaks or dampness.
The Process of Professional Mold Removal
The process of professional mold removal typically involves the following steps:
-
Assessment: The mold remediation company will assess the extent of the mold growth and determine the best course of action.
-
Containment: The affected area will be contained to prevent the mold from spreading to other areas of the home.
-
Removal: The mold will be physically removed from the affected area using specialized equipment and techniques.
-
Cleaning: The affected area will be thoroughly cleaned to remove any remaining mold spores.
-
Prevention: The underlying cause of the mold growth will be addressed to prevent future mold growth.
It is important to note that mold remediation can be costly, with prices ranging from a few hundred to several thousand dollars depending on the extent of the mold growth and the required remediation measures. However, the cost of professional mold remediation is often worth it to ensure that the mold is properly removed and the affected area is safe for occupancy.
Coping with Mold-Related Health Issues
Mold exposure can cause a wide range of health issues, including insomnia and other sleep-related problems. Coping with mold-related health issues can involve medical treatment and lifestyle changes.
Medical Treatment for Mold-Related Illnesses
Medical treatment for mold-related illnesses can include antifungal medications, immunotherapy, and other medications to alleviate symptoms. Chronic inflammatory response syndrome (CIRS) is a condition that can develop from mold exposure, and it can cause symptoms similar to fibromyalgia and other autoimmune diseases. Treatment for CIRS can involve a combination of medications and lifestyle changes to alleviate symptoms.
Lifestyle Changes to Alleviate Symptoms
Lifestyle changes can help alleviate symptoms of mold-related illnesses. These changes can include reducing exposure to mold, improving indoor air quality, and reducing inflammation through diet and exercise. It’s important to identify and remove sources of mold in the home, such as leaky pipes or water damage. Improving indoor air quality can involve using air purifiers and maintaining proper ventilation. A diet rich in anti-inflammatory foods, such as fruits, vegetables, and omega-3 fatty acids, can help reduce chronic inflammation and alleviate symptoms.
Overall, coping with mold-related health issues can involve a combination of medical treatment and lifestyle changes. It’s important to work with a healthcare provider to develop a treatment plan that is tailored to individual needs and symptoms.
Frequently Asked Questions
What are the potential health risks of mold exposure in the bedroom?
Mold exposure in the bedroom can lead to a variety of health problems, including respiratory issues, allergies, and skin irritation. In some cases, mold exposure can also cause headaches, fatigue, and difficulty concentrating.
Can exposure to mold contribute to the development of sleep apnea?
While there is no direct link between mold exposure and sleep apnea, exposure to mold can cause respiratory issues that may aggravate sleep apnea symptoms. In addition, mold exposure can lead to other sleep disturbances, such as snoring and difficulty falling asleep.
How can mold in the home affect cognitive and neurological health?
Mold exposure has been linked to a variety of cognitive and neurological problems, including memory loss, difficulty concentrating, and confusion. In some cases, mold exposure can also lead to depression and anxiety.
What psychiatric symptoms might be linked to mold toxicity?
Mold toxicity has been linked to a variety of psychiatric symptoms, including mood swings, irritability, and aggression. In addition, mold exposure can cause anxiety and depression, as well as other psychological symptoms.
Are there specific warning signs that suggest mold toxicity could be affecting my health?
Some of the warning signs that mold toxicity may be affecting your health include respiratory problems, skin irritation, headaches, and fatigue. In addition, if you notice a musty smell in your home or see visible signs of mold growth, such as black or green spots on walls or ceilings, it is important to take action to address the problem.
Is it possible for mold exposure to lead to severe health complications, such as brain infections?
While it is rare, severe mold exposure can lead to serious health complications, such as brain infections. This is more likely to occur in individuals with weakened immune systems, such as those with HIV/AIDS or cancer, or in individuals who have undergone organ transplants. However, it is important to note that most people who are exposed to mold will not experience severe health complications.